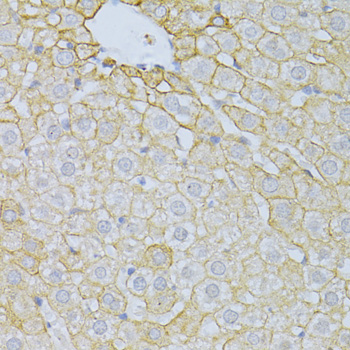
Immunohistochemistry - PLA2R1 Polyclonal Antibody

-
Product Name
PLA2R1 Polyclonal Antibody
- Documents
-
Description
Polyclonal antibody to PLA2R1
-
Tested applications
WB, IHC
-
Species reactivity
Human, Mouse, Rat
-
Alternative names
PLA2R1 antibody; CLEC13C antibody; PLA2-R antibody; PLA2G1R antibody; PLA2IR antibody; PLA2R antibody; phospholipase A2 receptor 1 antibody
-
Isotype
Rabbit IgG
-
Preparation
Antigen: Recombinant fusion protein containing a sequence corresponding to amino acids 870-1130 of human PLA2R1 (NP_031392.3).
-
Clonality
Polyclonal
-
Formulation
PBS with 0.02% sodium azide, 50% glycerol, pH7.3.
-
Storage instructions
Store at -20℃. Avoid freeze / thaw cycles.
-
Applications
WB 1:500 - 1:2000
IHC 1:50 - 1:200 -
Validations

Western blot - PLA2R1 Polyclonal Antibody
Western blot analysis of extracts of various cell lines, using PLA2R1 antibody at 1:1000 dilution.Secondary antibody: HRP Goat Anti-Rabbit IgG (H+L) at 1:10000 dilution.Lysates/proteins: 25ug per lane.Blocking buffer: 3% nonfat dry milk in TBST.Detection: ECL Basic Kit .Exposure time: 90s.
Immunohistochemistry - PLA2R1 Polyclonal Antibody
Immunohistochemistry of paraffin-embedded rat liver using PLA2R1 antibody at dilution of 1:100 (40x lens).
-
Background
Receptor for secretory phospholipase A2 (sPLA2). Acts as a receptor for phosholipase sPLA2-IB/PLA2G1B but not sPLA2-IIA/PLA2G2A. Also able to bind to snake PA2-like toxins. Although its precise function remains unclear, binding of sPLA2 to its receptor participates in both positive and negative regulation of sPLA2 functions as well as clearance of sPLA2. Binding of sPLA2-IB/PLA2G1B induces various effects depending on the cell type, such as activation of the mitogen-activated protein kinase (MAPK) cascade to induce cell proliferation, the production of lipid mediators, selective release of arachidonic acid in bone marrow-derived mast cells. In neutrophils, binding of sPLA2-IB/PLA2G1B can activate p38 MAPK to stimulate elastase release and cell adhesion. May be involved in responses in proinflammatory cytokine productions during endotoxic shock. Also has endocytic properties and rapidly internalizes sPLA2 ligands, which is particularly important for the clearance of extracellular sPLA2s to protect their potent enzymatic activities. The soluble secretory phospholipase A2 receptor form is circulating and acts as a negative regulator of sPLA2 functions by blocking the biological functions of sPLA2-IB/PLA2G1B.
Related Products / Services
Please note: All products are "FOR RESEARCH USE ONLY AND ARE NOT INTENDED FOR DIAGNOSTIC OR THERAPEUTIC USE"
